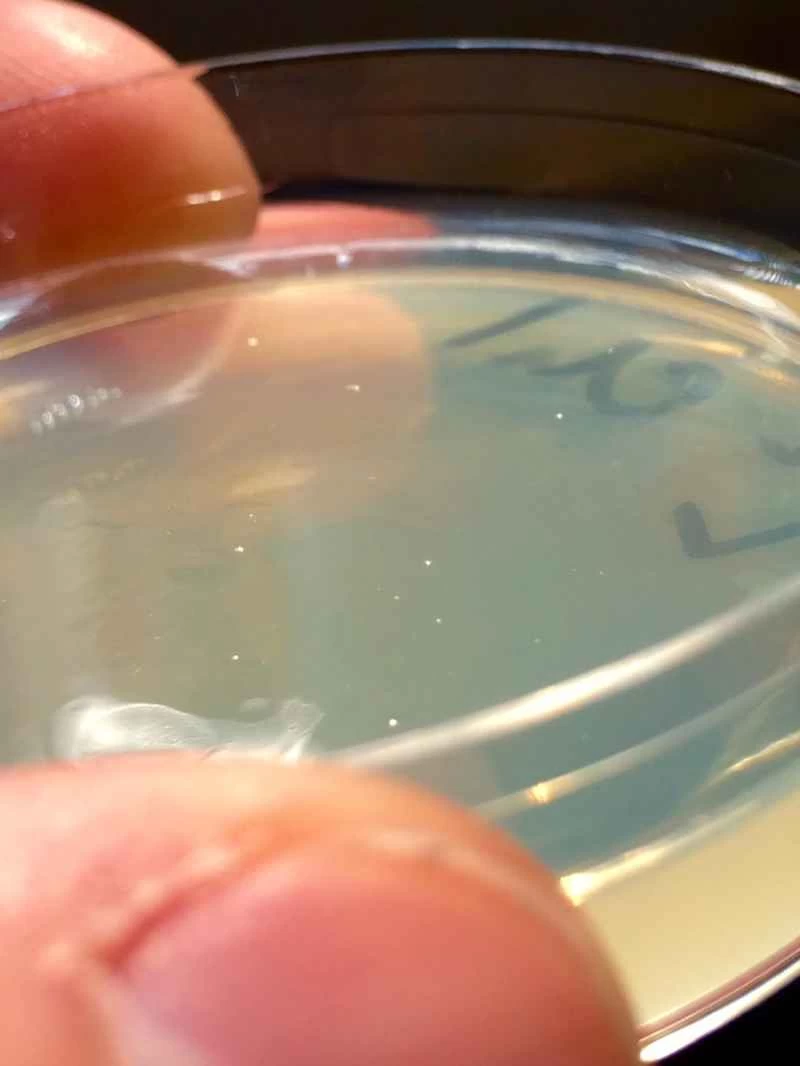
含有紅色和藍色螢光基因的大腸桿菌

一群人手捧盛滿啤酒的紅色杯子,圍坐在一張廚房桌子旁,桌上散落著培養皿、移液管和其他基本的實驗室設備。我們的東道主兼實驗室主任賈斯汀·帕哈拉解釋說,我們將把一段客製化的DNA片段植入一些毫無防備的大腸桿菌中。實際上,我們即將在德州奧斯汀的一間廚房裡對一個活細胞進行重編程。
我們戴了乳膠手套以防萬一,但其實沒必要;現場並非無菌環境,細菌也不危險。 (後面甚至還放了兩個啤酒桶,以防有人在操作過程中口渴。)
這是2015年西南偏南大會上由Synbiota主辦的一場生物駭客派對的場景——Synbiota是眾多推動DIY或車庫生物學運動的組織之一。與開源的電腦駭客風格類似,DIY生物學中心秉持著這樣的理念:消費者和個人應該能夠在實驗室之外進行生物過程和遺傳資訊的實驗。這些生物駭客認為,將實驗室工作局限於大型生物製藥公司和學術機構會扼殺創新,而基因工程的靈光乍現可能就來自一兩個人在自家車庫裡擺弄基因密碼。
合成生物學是這項運動的基石。 2006年, 《經濟學人》雜誌將這項技術描述為「將來自不同生物體的基因組裝起來,以創造新的代謝途徑,甚至創造新的生物體」。簡而言之,它是一種繞過緩慢進化過程的方法,透過在模式生物中混合搭配基因,來探索可能的創造方式。
並非所有政府都支持這種理念。在英國,個人需要獲得政府批准才能進行DNA實驗。同時,德國正在考慮全面禁止基因改造生物。美國的相關法律仍然相當寬鬆,這讓像羅伯特·卡爾森(Bioeconomy Capital的總經理,也是“車庫生物學”的支持者之一)這樣的美國生物黑客感到高興。
在西南偏南大會(SXSW)的合成生物學研討會上,卡爾森警告說,對基因工程進行嚴格監管會造就一個類似《絕命毒師》的世界。 「無論如何,人們都會嘗試這些東西,」卡爾森說。 「通常情況下,當你把某些事情定為非法時,你不會創造安全感,反而會製造不安全感和恐懼。你不希望人們隱瞞或不敢談論他們在做什麼。”
Synbiota 的目標是支持家庭基因工程實踐,並鼓勵有抱負的生物駭客加入「車庫生物學」運動。自 2011 年以來,該公司生產了各種 DIY 生物駭客套件,提供創建重組或手動建造 DNA 所需的軟硬體。這些套件涵蓋了從入門級生物學(例如將大腸桿菌重編程為紅色螢光)到快速建立複雜基因迴路的 DNA 原型等各種應用。這些套件的最終目標是簡化操作:讓基因改造過程更加方便快速。
「兩天之內,你就能設計出一個基因序列,把它組裝起來,植入細菌,然後重新啟動它,」麻省理工學院媒體實驗室主任伊藤簍一本週末在西南偏南合成生物學研討會上說。 “幾年前,這可是能拿諾貝爾獎的成就。現在,你甚至可以在廚房裡完成。”
我們正是這麼做的。在開始之前,Synbiota 的營運長帕哈拉詳細講解了每個步驟。我們使用了 Synbiota 的 Rainbow Factory 試劑盒(售價 395 美元),它可以混合搭配不同的螢光蛋白,使大腸桿菌發出絢麗多彩的螢光。我選擇了紅色和藍色螢光蛋白,來製造一個發出紫色螢光的細胞。然後,我利用該公司提供的 DNA 建構軟體,繪製出了基因序列圖譜,並開始進行實驗。
我們手裡都拿著啤酒,從錨定DNA——序列中的第一個連接點——開始。我們小心翼翼地用移液管將遺傳物質吸取到一個小的塑膠蓋中,然後用水沖洗,去除DNA中的污染物。接下來的步驟很簡單。我們加入下一個DNA序列以及連接酶,這種酶可以幫助DNA鏈「連接」在一起。每次添加新的連接點後,我們都會沖洗材料並重複上述步驟。
最後,我們加上了DNA帽,連接了DNA鏈的兩個開放末端。由此形成的環狀遺傳密碼稱為質粒,這就是我們重編程大腸桿菌所需的資訊。帕哈拉將質粒插入細菌,瞧!這些細菌很快就會變成發出紫色螢光的細胞。
更新:經過 48 小時多一點的時間,我們重編程的大腸桿菌綻放出美麗的紫色。請查看下方成品(我們的細菌構成了“PopSci”中的“P”和“I”),以及我們質粒的虛擬組成:


《大眾科學》雜誌正在德州奧斯汀的西南偏南大會現場,為您帶來最新的科技和文化資訊。請造訪 popsci.com/sxsw 查看我們的完整報導。